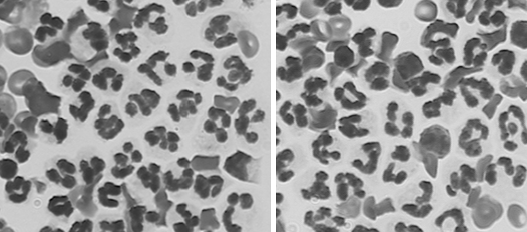

4์ฃผ์ฐจ (3/28) : I
Inflammatory CNS disease (์ผ์ฆ์ฑ ๋์งํ)
- Granuloma : ๊ฐ์ผ์ด ์๋ ์ํ์์ macrophage & lymphocyte๊ฐ ํผ์ฌ๋ ์ํ๋ก ์กด์ฌ.
- ์ผ์ฆ์ธํฌ๊ฐ ๋ง์ด ์กด์ฌ โ ๋น์ค(SG) ๋์, protein ๋๋ ๋์.
- Mononuclear cell(๋จํต์ธํฌ) ์ฆ๊ฐ - ์ฃผ๋ก monocyte, lymphocyte ์ฆ๊ฐ
- GME๋ ๋๋ถ๋ถ lymphocyte ์นจ์ค (T๋ฆผํ๊ตฌ > B๋ฆผํ๊ตฌ)
| Inflammatory CNS disease | |
|---|---|
| Infectious | Non-infectious |
| - Fungal : ์ฐ๋ฆฌ๋๋ผ๋ rare. - Bacterial : uncommon - Protozoal : uncommon - Babesiosis - Rickettia : uncommon | - Immune mediated, autoimmune : common |
CSF
CSF : cerebrospinal fluid (๋์ฒ์์ก)
- ๋ง๊ณ (clear) ํฌ๋ช (colorless)
- Protein content : < 20mg/ml
- WBC : < 6cells/ul ์ดํ๋ก ์กด์ฌ
- small lymphocyte๊ฐ ๋ง์
- ๋์ : < 173 mmH2O
| CSF ์๊ฒฌ | |
|---|---|
| Increased cells & porteins ๋ ๋ชจ๋ ๊ณตํต !! | |
| Inflammatory | - ์ผ์ฆ, ๋ฐ์ด๋ฌ์ค์ฑ ์งํ : โ๏ธ cell count : > 6cells/ul โ๏ธ ๋จ๋ฐฑ์ง ๋๋ : > 25mg/ml โ๏ธ Mononuclear cells ์ฆ๊ฐ (lymphocytes, reactive macrophages) |
| Fungal | - Cryptococcosis : โ๏ธ Mixed cell population (lymphocyte, reactive macrophage, neutrophils ๋ฑ์ด ํผ์ฌ) โ๏ธ Capsulated, budding yeast๊ฐ ๋ณผ๋ก ๋ณด์ |
| Bacterial | - Septic spinal tap โ๏ธ Neutrophil์ด ํจ์ฌ ๋ง์ โ๏ธ cultureํด์ ์ธ๊ท ํ์ธ |
| Neoplasia | - Lymphosarcoma๊ฐ ๋ง์ โ๏ธ neoplastic cells ์ฆ๊ฐ (choroid plexus papillomas, ependymomas, lymphosarcoma์์ ๋ํ๋จ) |
CSF Titer ๊ฒ์ฌ : Viral & Protozoal
- ํ์ฒญ์์์ titer์ ๋์ฒ์์ก์ titer๋ฅผ ๋น๊ต ํ๊ฐ (paired serum and CSF)
- Before/After๋ฅผ ๋น๊ต. 2์ฃผ ๊ฐ๊ฒฉ์ผ๋ก ๊ฒ์ฌํ์ฌ ์์น๊ฐ 4๋ฐฐ ์ด์ ์ฌ๋ผ๊ฐ๋ฉด ๊ฐ์ผ๋ ๊ฒ.
- ์ง๊ธ์ ์ ์ ์ด๋ค. CSF ๋ฝ์์ real-time PCR ๋๋ฆฌ๋ฉด ๋๋๊น..
| ํ์ฒญ | CSF | ๊ฒฐ๊ณผ |
|---|---|---|
| ๋์ | ๋ฎ์ | ๋ฐฑ์ ๊ฐ๋ฅ์ฑ โ |
| ๋์ | ๋์ (ํนํ 2์ฃผ ๋ค ํจ์ฌ ์ฆ๊ฐํ์ผ๋ฉด) | ๊ฐ์ผ ๊ฐ๋ฅ์ฑ โ (BBB ํต๊ณผ) |
| CSF Titer | |
|---|---|
| ์ผ์ฆ์ ์ฆ๊ฑฐ๊ฐ ์๋ ์๋ ๊ฒ์ฌ | |
| Viral | - Canine distemper / FeLV, FIP |
| Protozoal | - Toxoplasma, Neospora caninus (๋๊น์ง ๋๋ฌ) |
| ์ผ์ฆ์ ์ฆ๊ฑฐ๊ฐ ์์ ๋ ๊ฒ์ฌ | |
| Fungal | - Aspergillus / Cryptococcus |
| Rickettsial | - RMSF (Rocky Mountain Spotted Fever) / Erhlichia |
| Bacterial | - Borrelia (Borrelia burgdorferi ๊ฐ์ผ โ Lyme disease) |
๐ Case 1 : Bacterial Meningoencephalitis
S
4y, Male, Miniature pinscher
- 5.4kg, 39.0โ, 150ํ/min (์ ์ ์ฒด์จ, ์ ์ ์ฒด์ค)
- Acute onset : stiffness, head tilt, nystagmus
โ ์ ํ์ ์ธ vestibular sign
- Lt. side SLMN swelling (1๋ฌ ์ ) โ ํญ์์ ํฌ์ฌ ํ ๊ฐ์ , ์ธ๊ท ๊ฐ์ผ ์ถ์
(SLMN = Spinal Lower Motor Neuron, ์ฒ์ ํ์ ์ด๋ ๋ด๋ฐ)
O
| Physical exmination |
|---|
| - Left side head tilt, tetraparesis - Horizontal & Positional nystagmus โ CN โ ข, โ ฃ, โ ฅ & โ ง - Delayed postural reactions - Delayed PLR โ CN โ ก & โ ข - Reduced gagging reflex โ CN โ จ & โ ฉ (์นจ ์ผํด ๊ด๋ จ ์ ๊ฒฝ) โ ๋ ์ ์ฒด์ multifocalํ๊ฒ ๋ฌธ์ (Brain & Brainstem) |
ํด๋ถ2 - ๋์ ๊ฒฝ ์ ๋ฆฌ ํ
| Blood examination |
|---|
| Moderate neutrophilic leukocytosis |
| EEG |
|---|
![]() |
| Brain CT |
|---|
![]() |
| ๋ ์์์ multifocal ์ผ์ฆ ์๊ฒฌ (์๋, ์ค๋, ๋์ค๊ธฐ ์์ญ์ ํ์๊ฒ ์ผ์ฆ) |
![]() |
| - ๊ณ ํด์๋(0.2T)๋ก ๋ณด๋, ์๋์ ์ฐ์์ ์ฐ๊ฒฐ ๋ถ์์์ ์ฌํ ๋ณ๋ณ (vestibular sign ๊ด๋ จ) (*์ ์ ์ชฝ ๋ณ๋ณ : ์๋ ์ผ๋ถ, flocculondular lobe, medulla oblangata, ๋ด์ด) - ๊ทธ ์ธ ๋์ค๊ธฐ, ๋๋ ๋ฐ๊ตฌ์์๋ ์ฌํ ์ผ์ฆ ์๊ฒฌ. |
| โ Midbrain + diencephalon์ multifocalํ ์ผ์ฆ ์๊ฒฌ. (๋์๋ง์ผ) |
| CSF ๊ฒ์ฌ |
|---|
![]() |
| - Neutrophilic pleocytosis (neutrophil๋ง ์์ฒญ ๋์ด)โ Bacteria ๊ฐ์ผ ์์ฌ. - ์ธ๊ท ๊ฐ์ผ ์ โ ํ๋์ฑ(suppurative) ๋ณ๋ณ = neutrophil ๋ง์. - ํญ์์ ํฌ์ฌ ํ ๋ฆผํ์ ๋น๋๊ฐ ํด์๋์๋ ๊ฒ๋ ์ธ๊ท ์ฑ ๊ฐ์ผ ์ถ์ ์ ๊ทผ๊ฑฐ |
| โ ์ธ๊ท ๊ฐ์ผ์ผ๋ก ์ธํ active intracranial inflammation |
A
Dx) Bacterial meningoencephalitis (BME, ์ธ๊ท ์ฑ ๋์๋ง์ผ)
(๋ง์ฝ ๋ฉด์ญ ์ต์ ์ ๋ฅผ ํจ๋ถ๋ก ์ผ๋ค๊ฐ ์๊ณ ๋ณด๋ ์ธ๊ท ๊ฐ์ผ์ด๋ฉด ๋งค์ฐ ์ฌ๊ฐํด์ง โ ์ธ๊ท ๊ฐ์ผ์ธ์ง ๋ช
ํํ ๊ฐ๋ณ ์ค์.)
P
- ํญ์์ ์ ํ? โ ๋์ฒ์์ก์ผ๋ก 16s rRNA real-time PCR ๊ฒ์ฌํ์ฌ ์ธ๊ท ๋์
- Culture๋ณด๋ค ๋น ๋ฅด๊ณ ์ ํํจ
- ๋ง์ฝ ํญ์์ ๋ฅผ ์ผ๋๋ฐ ์น๋ฃ ๋ฐ์์ด ์์ผ๋ฉด SRMA ์์ฌ
- SRMA (Steroid-Responsive Meningitis-Arteritis) : ๋น๊ฐ์ผ์ฑ(immune-mediated)์ผ๋ก ์ฌ ์ ์์.
- Steroid์ ๋ฐ์ํ์ฌ ํธ์ค๊ตฌ ๊ฐ์
โ BBB ํต๊ณผํ๋ ํญ์์ ์ฒ๋ฐฉ ์ผ๋ก ์น๋ฃ๋จ. (์ ๊ฑธ์) (๋ง์ฝ ์คํ ๋ก์ด๋ ํจ๋ถ๋ก ์ผ์ผ๋ฉด ์ฃฝ์์ ์๋..)
(์ธ๊ท ์ด ๋์ ์ผ์ฆ์ ์ ๋ฐํ ์ ์๋ค๊ณ ๋ณด๊ณ ํ ๊ตญ๋ด ์ต์ด ์ผ์ด์ค)
Pug dog-meningoencephalitis
- Pug์์ GME, NME๊ฐ ์ ์๊น.
- ๋์ฒ์์ก ์์์ macrophages, lymphocytes ๋ง์ด ๊ด์ฐฐ๋จ.
SRMA (CRTS) : ์น๋ฃ ๋ฐฉํฅ ๋ฐ๋
CRTS (Corticoid-responsive tremor syndrome)
- Tremor ์ฆ์์ด ์์๋๋ฐ, ์คํ ๋ก์ด๋ ์ฝ๋ฌผ์ ๋ฐ์ํ์ฌ ๋จ์ง ์์.
- MRI ๊ฒฐ๊ณผ์๋ ๋ํ๋์ง ์์ง๋ง, ์คํ ๋ก์ด๋ ๋จน์ด๋ฉด ์ข์์ง๋๋ผ
- ๊ณผ๊ฑฐ์๋ ํธ์ด ํ์ ์ ๋คํํ ๋ง ์๊ฒจ์ white shaker syndrome์ด๋ผ๊ณ ํ์ผ๋,
- ์ํฌ์ ํ ๋ฆฌ์ด์ฒ๋ผ ํธ์ด ํ์์ง ์์ ๊ฐ์์๋ ๋ํ๋์ โCRTSโ๋ก ๋ฐ๋.
SRMA (Steroid responsive meningitis-arteritis / Suppurative meningitis & arteritis)
(Neutrophil์ด ๋ง์์ suppurativeํ๊ฒ ๋ํ๋จ)
- Steroid ์ฐ๋ฉด dramaticํ๊ฒ ์ข์์ง. but ์ธ๊ท ๊ฐ์ผ์ ์๋์ง ํ์คํ ๊ตฌ๋ณํด์ผ ํจ!
- MRI์ ๋ํ๋๋ ์ด์์ ์์ง๋ง, ๋์ฒ์์ก์ neutrophil ์ฆ๊ฐ (pleocytosis) โ ๋์๋ง์๋ง ์ผ์ฆ์ด ์จ ๊ฒ์ผ๋ก ์ฌ๊ฒจ์ง (meningitis)
- CRTS = SRMA ๋ผ๊ณ ์๊ฐ๋จ.
5์ฃผ์ฐจ (๋
น๊ฐ) : I
GME (Granulomatous meningoencephalitis)
์ก์์ข ์ฑ ๋์๋ง์ผ.
- ๋น์ผ์ฆ์ฑ ๋์๋ง์ผ์ ์ ๋ฐ.
- Small breed dog์์ ๋ง์ด ๋ฐ์ - ํธ๋ค, ๋งํฐ์ฆ, ํผ๊ทธ, ์ํฌ์ ํ ๋ฆฌ์ด ๋ฑ
- ์ ์ ๋์ด์ ๋ง์ด ๋ฐ์ํ๋ฉฐ ๋งค์ฐ ์น๋ช ์ , ์ค๋ ๊ธฐ๊ฐ ์น๋ฃ ํ์.
๐ Case 2 : GME
- Generalized tonic-clonic seizure์ด ์๋ ํธ๋ค.
- ์์์ด ์์, ์ ๊ฒฝ ๊ฒ์ฌ ๊ฒฐ๊ณผ ๋์ง๋ณ ์์ฌ
- Brain MRI ๊ฒฐ๊ณผ ์ก์์ข ์ฑ ๋์๋ง์ผ ์๊ฒฌ (์ข ์์ฒ๋ผ ๋์ ์๊ธด ํ์ ๋ถ๋ถ๋ค)

- ๋์ ์ ์ฒด์ multifocalํ๊ฒ ๋ณ์๊ฐ ์กด์ฌํจ. โ ์์ ์ฆ์, ์ํ๊ฐ ๋์๊ฒ ๋ค
- ์ด๋ฌํ ์ผ์ฆ์ฑ ๋ณํ๋ก tonic-clonic generalized seizure๋ฅผ ๋ณด์.
- ์ด๋ ๊ฒ Forebrain ์ ๋๋ฐ๋๋ฉด โ seizure ๊ฐ์๊ธฐ ๋ฐ์, ์ฅ๊ธฐ๊ฐ ๋ฉด์ญ ์ต์ ์ ์ฌ์ฉ.
- lymphocyte๊ฐ ๋์ ํ๊ด ์ฃผ๋ณ์ ์นจ์คํ๊ธฐ ๋๋ฌธ์ ๋น๊ฐ์ผ์ฑ ๋์๋ง์ผ์ผ๋ก ๋ถ๋ฅ, immune-mediate๋ autoimmune encephalitis๋ก๋ ์์ฌํจ.
- ์ฌ๋์ multiple sclerosis (๋ค๋ฐ์ฑ ๋๊ฒฝํ์ฆ) ๊ณผ ๊ฐ์ ์ง๋ณ.
S
4y, NM, poodle
- 5.8kg / 38.3 Cโ / 120bpm
- CC : Generalized tonic-clonic seizures, Dyspnea
- RIght-side hemiparesis(ํธ์ธต์ฑ ๋ง๋น)
- No postural reactions of Rt. side
- Head tilt
- No PLR, No MR (Menace response, ์ํ ๋ฐ์ฌ)
- Horizontal nystagmus, ์์ชฝ ๋์ miosis โ Forebrain sign & vetibular sign, ๋ ์ ์ฒด์ multifocalํ ๋ณ๋ณ
O
| CSF analysis |
|---|
![]() |
| - Color : ๋ง์(colorless) - Protein : >300mg/dL โ ๋์ ํธ - Nucleated cell count : >100cells/ฮผl โ ๋ฐฑํ๊ตฌ ์ฆ๊ฐ - Mononuclear pleocytosis (monocytes, lymphocytes ์ฆ๊ฐ) [2๋ฒ์งธ ์ฌ์ง] - Bacterial, fungal culture, Toxo, Ehrlichia : X |
| โ ๊ฐ์ผ์ฑ ์์ธ์ฒด X / ๋์ ์ผ์ฆ์ฑ ์นจ์ค ์กด์ฌ |
| MRI | |
|---|---|
![]() | ์ผ์ชฝ ๊ฐ์ชฝ๋์ค ์ ๋ณด์. ์ผ์ชฝ ๋ ์ ์ฒด์ ์ฌํ ์ผ์ฆ์ฑ ์๊ฒฌ |
![]() | ๋์ฒ์์ก ์ธ์ ๋ถ๋ถ์์๋ signal ์ฆ๊ฐ ๋๋ ์ ์ฒด์ multifocalํ ์ผ์ฆ ๋ฐ์ |
![]() (๋ชจ๋ฅด๊ฒ ๋ค๊ณ ? ๋๋ ๊ทธ๋..) | ์ผ์ชฝ์์ ๊ฐ์ชฝ๋์ค ์ ์ ๋ณด์, ์ผ์ฆ์ ์ํ edema. linearํ๊ฒ ๊ตญ์์ ์ธ ์กฐ์ ์ฆ๊ฐ โ ํ๊ด์ ์ผ์ฆ์ ์๋ฏธ * solitary, ๋ช ํํ๊ฒ ๊ตฌ๋ณ๋๋ ์กฐ์ ์ฆ๊ฐ โ ์ข ์ * linear/diffuse ํํ์ ์กฐ์ ์ฆ๊ฐ โ ํ๊ด ์ผ์ฆ |
| Histopathology | |
|---|---|
![]() | ํ๊ด ์ฃผ๋ณ์ผ๋ก lymphocyte ์นจ์ค๋์ด ์์. (Immune-mediated) |
A
- forebrain sign & vetibular sign
- CSF์ ๋ฐฑํ๊ตฌ, ๋จํต๊ตฌ ๊ณํต ์ธํฌ ์ฆ๊ฐ
- MRI์ ๋ ์ ๋ฐ์ multifocalํ ์ผ์ฆ
โ Dx) GME (Granulomatous Meningoencephalitis) (I - Immune mediated)
P
GME ์ง๋จ ์ combination therapy
- prednisolone (1mg/kg BID PO) : ์ผ์ฆ ๊ฐ์
- ์ฅ๊ธฐ๊ฐ ์ฌ์ฉ ์ ์์ธ์ฑ cushing ์ฆ์ (PUPD, ๋ฐฐ๊ฐ ๋นต๋นต, ํ๋ชจ, ํผ๋ถ ๊ฑด์กฐ/์์์ง), ๋น๋จ, ๊ฐ๋ง ๊ถค์, ํผ๋ถ ์นผ์ ์นจ์ฐฉ
- ์ฅ๊ธฐ๊ฐ ์ฌ์ฉ ์ ์ฉ๋์ ๋ฎ๊ฒ ์จ์ผ ํจ (1mg/kg ์ดํ)
- ๊ทธ ์ธ์๋ GME ํ์์์๋..
- cyclosporine (5-10mg/kg BID PO) : ๋ฉด์ญ ์ต์ ์ (์ฅ๊ธฐ์ด์ ๊ฑฐ๋ถ๋ฐ์ ์ต์ ๋ฑ), ์ง์ฉ์ฑ ์ฝ๋ฌผ๋ก ํ์ฌ๋ง๋ค ํก์์จ์ด ๋ค๋ฅด๋ฏ๋ก ํ์ค ๋๋ ์ธก์ ํ๋ฉฐ ์ฌ์ฉํด์ผ ํจ.
- misoprostol (3ฮผg/kg BID PO) : ์๋ฒฝ ๋ณดํธ (steroid์ ์ํ ์๊ถค์ ์๋ฐฉ)
- silymarin, sucralfate, UDCA : ์ ๋ง ๋ฐ ๊ฐ ๋ณดํธ, ๋ด์ฆ ๋ฐฐ์ค ์ด์ง (steroid์ ์ํ ๊ฐ๋ ์ฑ ์๋ฐฉ)
Progress note
- 1์ฐจ Medication | PDS ํฌ์ฌ โ ์์์ฆ์ ๊ฐ์ , ataxia/recumbency ์ํ โ ๋ค์ ์ผ์ด๋ ๊ฑธ์
- Combination therapy | PDS + cyclosporine ํฌ์ฌ
- Progress | mental status & neurologic sign ๊ฐ์ , ํนํ seizure ๊ฐ์
โ P) ์ผ์ฆ์ ์ํ active seizure์ ํด๋นํ๋ ๊ฒ์ ํ์ธ, ํญ๊ฒฝ๋ จ์ ์ ๊ธฐ์ ์งํ ์น๋ฃ ์ด์ด๋๊ฐ์ผ ํจ.
๋ค์ํ meningoencephalitis
- GME (Granulomatous meningoencephalitis) : ์ฃผ๋ก ๋ฆผํ๊ตฌ๊ฐ ๋ณ๋ณ์ ์นจ์คํ์ฌ ๋น๊ฐ์ผ์ฑ์ผ๋ก ๋ฐ์ํ ๋์๋ง์ผ.
- Granulomatous = lymphocytes, macrophages, monocytes, neutrophils๊ฐ ํผ์ฌ๋์ด ๋ํ๋ ๊ตฌ์กฐ.
- ์ด๋ฐ ์ก์์ข ์ฑ ์ผ์ฆ์ด CNS์ ๋ถํฌํจ.
- NME (Necrotisizing meningoencephalitis) : ๋ฆผํ๊ตฌ๊ฐ ์นจ์คํ์ฌ ๋ ์ผ๋ถ์ ๊ดด์ฌ๊ฐ ์งํ, GME๋ณด๋ค ์
ํ๋ ์๊ฒฌ.
- Pug meningoencephalitis : pug์ ํธ๋ฐํ์ฌ ๋ถ์ ์ด๋ฆ, ๊ณผ๊ฑฐ์ ์ฌ์ฉ
- CDV-meningoencephalitis : Distemper virus์ ์ํ viral meningoencephalitis
- Mucoencephalitis : ์ฃผ๋ก white matter์ ์ ์ก์ฑ ์ผ์ฆ์ด ๋ํ๋์ ๋ถ์ ์ด๋ฆ
- ์์ธ์ ์ฐพ์ง ๋ชปํ ๊ฒฝ์ฐ, MUE (Meningoencephalitis or unknown etiology)
- Pons-medullary GME : seizure๋ ๋ฐ์ํ์ง ์๊ณ ํธํก ๊ณค๋, ์์จ์ ๊ฒฝ๊ณ ์ด์, cranial nerve ์ด์, ๋น๋งฅ์ฑ ๋ถ์ ๋งฅ์ด ๋ฐ์ํจ.
Types of GME
| Types | |
|---|---|
| Ocular form | Optic nerve์ ์ผ์ฆ์ด optic neuritis๋ฅผ ์ ๋ฐํ์ฌ ์๊ฐ ์ฅ์ |
| Focal form | ํ ๊ตฐ๋ฐ์ ๋ณ๋ณ์ด ์๋ ๊ฒฝ์ฐ |
| Multifocal form | ์ฌ๋ฌ ๊ตฐ๋ฐ ๋ณ๋ณ์ด ์๋ ๊ฒฝ์ฐ |
| Disseminated form | ๋๋ฟ๋ง ์๋๋ผ ๋, optic nerve, brain stem, spinal cord ๋ฑ์ ๋ค์ํ๊ฒ ๋ฐ์ํ ๊ฒฝ์ฐ |
| ์ฌ์ง์ผ๋ก ๋ณด๋ ๋ค์ํ ๋์๋ง์ผ ์ผ์ด์ค | |
|---|---|
![]() Sagittal T2-weighted image of GME case | - frontal lobe์ solitaryํ๊ฒ ๋ํ๋ hyperintense lesion โ Focal GME |
![]() enhanced T1 & T2 weighted image | - ๋ ์์ชฝ๊น์ง multifocal lesions ์์ - ์ข ์๊ณผ ํท๊ฐ๋ฆฌ์ง ์๋๋ก ์ฃผ์. โ Multifocal GME |
![]() GME case | - ์ผ์ชฝ ๋์ ์ ๋ฐ์ ์ผ๋ก ์ฌํ ์ผ์ฆ ์๊ฒฌ - autopsy ๊ฒฐ๊ณผ, cerebral parenchyma์ swelling - ๋น๋์นญ์ ์ธ ์ธก๋์ค ๊ด์ฐฐ๋จ |
![]() GME case์ histopathology | - A : perivascular cuffings (ํ๊ด ์ฃผ๋ณ์ผ๋ก ๊ฒ๊ฒ ๋ ๋ถ๋ถ๋ค์ด ๋ง์) - B : lymphoid cells ์นจ์ค (ํ๊ด ๋ด ํ์ ๊ณตํฌ๋ก ๋ํ๋๋ ์ง๋ฐฉ ๊ตฌ์กฐ๊ฐ ํฌ๋์ ๊ฐ์ด ํ๊ด์ ์ธ๊ณ ์์.) |
![]() NME (YT) | - T1 image์์๋ hyposignal (์ด๋ก๊ฒ ๋ณด์) - T2 image์์๋ hypersignal (๋ฐ๊ฒ ๋ณด์) โ NME ์ ํน์ง! * GME๋ T1์์ isoignal, T2์์ hypersignal |
![]() NME case | - ์ค๋ฅธ์ชฝ ๋์ temporal ์์ญ์ ๋ง์ ์ผ์ฆ ํ์ธ - ๋ถ๊ฒ ๊ฒฐ๊ณผ gray matter ์ผ๋ถ๊ฐ ์์ ํ ๊ดด์ฌ๋ ๊ฒ์ ํ์ธ |
Therapy & Prognosis of GME
| ์ฝ๋ฌผ | |
|---|---|
| Steroid (Prednisolone) | - ํญ์ผ ํจ๊ณผ๋ก ์ข์ - ์ฅ๊ธฐ๊ฐ ์ฌ์ฉ ์ ์์ธ์ฑ Cushing ์ํ - ์ ์ฐจ ๊ฐ๋ํ๋ฉด์ ์ต์ ์ฉ๋์ผ๋ก ์ ์ง |
| Cytosine arabinoside | - ์ค๋ซ๋์ ์ฌ์ฉ๋ ํญ์์ /๋ฉด์ญ์ต์ ์ - PDS์ ํจ๊ป ์ฌ์ฉ, ๋๋ ๋จ๋ ์ผ๋ก ๋ฉด์ญ ํญ์ง์ ์ํ GME ์น๋ฃ์ ์ฌ์ฉ - BBB๋ฅผ ํต๊ณผํ ์ ์์ - ๋ถ์์ฉ : ๊ณจ์์ต์, ๊ตฌํ , ์ค์ฌ, ํ๋ชจ ๋ฑ - ํผํ์ฃผ์ฌ, 50mg/mยฒ BID๋ก ์ดํ ์ฐ์, 3์ฃผ์ 1๋ฒ ๊ฐ๋ฅ - ์ฝ๋ฌผ์ด ํผ๋ถ๋ฅผ ํต๊ณผํ๊ธฐ ๋๋ฌธ์ ์ฅ๊ฐ์ ๋ผ๊ณ ํฌ์ฌ |
| Procarbazine | - PDS ๋ณด์กฐ ์๋ฒ, ๋จ๋
์ผ๋ก๋ ์ฌ์ฉ ๊ฐ๋ฅ - ํญ์ข ์ ์ฝ๋ฌผ, ์ง์ฉ์ฑ์ผ๋ก BBB ํต๊ณผ ๊ฐ๋ฅ - 25-50mg/mยฒ/day PO |
| Cyclosporine A | - IL-2๋ฅผ ๋น๋กฏํ cytokine ํฉ์ฑ ์ต์ - ์ฌ๋ฃ ์ญ์ทจ 1์๊ฐ ์ or 2์๊ฐ ํ์ ๋จน์ฌ์ผ ์ ํก์๋จ - ์์ ํ ํธ์ด์ง๋ง, ํ์ค ๋๋๊ฐ ๋๊ฒ(>3000ng/ml) ์ค๋ ํฌ์ฌํ๋ฉด ์ ๋ ์ฑ, ๊ฐ๋ ์ฑ - ํ์ค ๋๋ 200-400ng/ml์ ์ ์งํ๋ฉด ์ฅ๊ธฐ ์ฌ์ฉ ๊ฐ๋ฅ, ํฌ์ฌ 2์ฃผ ํ ํ์ค๋๋ ์ธก์ ๊ถ์ฅ. - ๋ถ์์ฉ : excessive shedding, gingival hyperplasia, hypertrichosis(ํธโ), ๊ตฌํ , ์ค์ฌ, ์์๋ถ์ง |
| Cyclosporine + Ketoconazole | - Cyclosporin A 5mg/kg + Ketoconazole 8mg/kg SID โ cyclosporine A ๋๋๊ฐ ์ ์ ์ง๋จ. - cyclosporine์ด ๋น์ธ์ ์ด๋ ๊ฒ ๋ณ์ฉํ๊ธฐ๋ ํจ. - ํ์ ๋๋์ ๋๋ฌํ๋์ง ํ์ธํ๊ณ ์ฝ๋ฌผ ํฌ์ฌ๋ ์กฐ์ - Ketoconazole์ ๊ฐ๋ ์ฑ์ด ์์ผ๋ฏ๋ก ๊ฐ์ด ์ ์ข์ ํ์์์๋ X |
| Leflunomide | - ๋ฉด์ญ์ต์ ์ , MMF๋ ์ฌ์ฉ ๊ฐ๋ฅ - 4mg/kg SID |